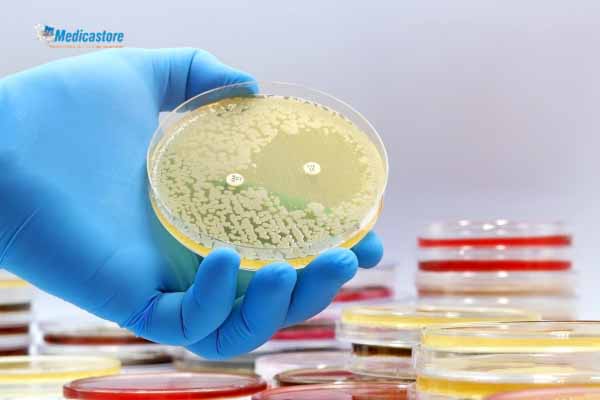
Apa Itu Resistensi Bakteri

Saat ini, isu resistensi bakteri menjadi salah satu tantangan besar di dunia medis. Banyak infeksi yang sebelumnya mudah diobati kini semakin sulit disembuhkan karena bakteri telah mengembangkan kemampuan untuk menolak efek obat antibiotik.
Kondisi ini menjadi perhatian penting bagi Anda sebagai pasien atau keluarga agar lebih sadar akan pentingnya pencegahan dan penanganan yang tepat. Melalui artikel ini, Medicastore ingin membantu Anda memahami secara jelas apa itu resistensi dari bakteri, hingga cara-cara untuk mengatasinya.
Apa Itu Resistensi Bakteri?
Resistensi bakteri adalah fenomena di mana bakteri mengalami perubahan, baik genetik maupun melalui mekanisme adaptasi lainnya, sehingga obat-antibiotik yang sebelumnya efektif tidak lagi mampu membunuh atau menghentikan pertumbuhan bakteri tersebut.
Dengan kata lain, bakteri menjadi kebal terhadap obat yang biasa digunakan. Contohnya, beberapa jenis bakteri gram-negatif kini menunjukkan resistensi terhadap antibiotik “lini terakhir” yang sebelumnya sangat diandalkan.
Ketika resistensi bakteri terjadi, infeksi yang seharusnya dapat diobati dengan relatif mudah bisa menjadi lebih panjang, lebih serius, dan berisiko komplikasi.
Data global menunjukkan bahwa pada tahun 2019 saja, sekitar 1,27 juta kematian secara langsung dapat diatribusikan kepada infeksi bakteri yang resisten. Lebih luas lagi, hingga 4,95 juta kematian terkait dengan kondisi di mana resistensi bakteri berkontribusi.
Mengetahui konsep resistensi bakteri sangat penting. Hal ini berpengaruh pada cara menggunakan antibiotik, menerapkan tindakan pencegahan di rumah, serta memahami bahwa pengobatan tidak bisa dilakukan sembarangan. Beberapa obat hanya boleh diperoleh dengan resep dokter dan digunakan sesuai petunjuk.
Penyebab Resistensi Bakteri
Ada beberapa faktor utama yang menyebabkan resistensi bakteri meningkat, dan Anda perlu memahami agar dapat mengambil tindakan preventif.
- Penggunaan Antibiotik yang Tidak Tepat
Ketika antibiotik diberikan padahal seharusnya tidak (misalnya infeksi virus), atau dosis dipakai kurang atau terlalu lama, bakteri dapat “belajar” bertahan.
- Penggunaan Antibiotik dalam Usaha Peternakan dan Agrikultur
Antibiotik sering digunakan secara luas dalam hewan ternak agar pertumbuhan lebih cepat atau mencegah infeksi, yang kemudian dapat berkontribusi pada resistensi bakteri di manusia.
- Kurangnya Pencegahan Infeksi dan Sanitasi yang Buruk
Lingkungan dengan kebersihan rendah atau fasilitas kesehatan dengan kontrol infeksi yang kurang dapat memfasilitasi penyebaran bakteri resisten.
- Kurangnya pengembangan antibiotik baru
Karena resistensi berkembang, namun pengembangan obat baru berjalan lambat, maka opsi pengobatan menjadi semakin terbatas.
Dengan memahami penyebab-penyebab ini, Anda bisa menjadi bagian dari solusi, misalnya dengan selalu menanyakan kepada dokter kapan penggunaan antibiotik benar-benar diperlukan, dan memastikan Anda menyelesaikan pengobatan sesuai instruksi.
Tanda Terjadi Resistensi Bakteri
Pada dasarnya, gejala infeksi bakteri yang mengalami resistensi tidak berbeda secara dramatis dari infeksi bakteri biasa, namun yang membedakan adalah apakah pengobatan berjalan lebih lambat atau tidak efektif.
Beberapa tanda yang patut Anda perhatikan:
- Jika Anda sudah mulai mengonsumsi antibiotik sesuai resep, tetapi kondisi tidak membaik dalam jangka waktu yang seharusnya, bisa jadi bakteri penyebabnya telah menjadi resisten.
- Infeksi yang semestinya singkat menjadi kronis atau berulang-ulang, misalnya luka yang lama sembuh, infeksi saluran kemih yang sering kambuh, atau pneumonia yang tidak merespon terapi.
- Gejala awal infeksi bakteri seperti demam, nyeri, bengkak, keluarnya nanah, atau perubahan warna pada luka tetap ada atau semakin memburuk meskipun sudah mendapat pengobatan.
Ketika Anda menemui gejala-gejala semacam ini, penting untuk segera menghubungi tenaga medis dan tidak menunda pengobatan atau mengganti antibiotik sendiri tanpa petunjuk dokter – karena itu bisa memperburuk kondisi resistensi.
Cara Mencegah Resistensi Bakteri
Mengatasi resistensi bakteri merupakan tugas bersama antara Anda sebagai individu, tenaga medis, dan sistem kesehatan. Berikut beberapa langkah yang bisa Anda lakukan sekarang:
1. Gunakan antibiotik hanya bila diresepkan oleh dokter, dan ikuti dosis serta durasinya dengan tepat. Antibiotik yang dibeli tanpa resep atau tidak digunakan sesuai petunjuk dapat memperkuat bakteri resisten.
2. Tingkatkan kebersihan diri dan lingkungan: cuci tangan secara rutin, jaga kebersihan luka, hindari kontak dengan orang sakit bila memungkinkan, dan pastikan Anda melakukan vaksinasi sesuai anjuran, karena mencegah infeksi artinya mengurangi kebutuhan antibiotik.
3. Patuhi tindakan kontrol infeksi di fasilitas kesehatan: Jika Anda dirawat di rumah sakit atau menjalani prosedur, pastikan fasilitas menggunakan protokol steril dan pencegahan infeksi yang baik.
4. Dukung penggunaan antibiotik yang bertanggung-jawab (antibiotic stewardship): Tenaga medis perlu memilih antibiotik yang tepat, memantau respons, dan jika perlu mengganti terapi. Dari sisi Anda, sejak awal tanyakan pada dokter manfaat dan risiko seperti apa yang Anda hadapi.
5. Pantau perkembangan dan laporkan jika pengobatan tidak berhasil: Jangan ragu untuk kembali ke dokter jika gejala tidak membaik atau malah memburuk, karena mungkin diperlukan pemeriksaan laboratorium atau penggantian terapi.
6. Dukung penelitian dan pengembangan obat baru: Meskipun ini langkah jangka panjang dan bukan tanggung jawab langsung Anda, sebagai konsumen Anda bisa memilih produk kesehatan dari penyedia yang mendukung riset atau memberi informasi terbuka.
Perlu diingat: obat?antibiotik keras (termasuk yang digunakan dalam infeksi bakteri resisten) hanya boleh digunakan atas resep dokter dan sesuai petunjuk. Obat semacam ini tidak boleh digunakan sembarangan atau dimiliki tanpa pengawasan medis.
Intinya, resistensi dari bakteri merupakan tantangan serius yang memengaruhi efektivitas pengobatan infeksi pada Anda dan orang terdekat. Dengan memahami apa itu resistensi bakteri, penyebab, gejala, serta cara penanganannya, Anda berada dalam posisi yang lebih kuat untuk mencegah dan menghadapi masalah ini.
Pengetahuan yang tepat akan membantu Anda berperan aktif dalam menjaga efektivitas pengobatan serta mencegah penyebaran bakteri resisten di lingkungan sekitar.
Benefit dan Dukungan dari Medicastore
Di Medicastore, kami menyediakan layanan informasi kesehatan yang akurat seperti informasi penyakit dan artikel kesehatan. Selain itu, di medicastore juga tersedia produk kesehatan terpercaya untuk memenuhi kebutuhan kesehatan Anda dan keluarga.
Kami hanya menyediakan obat antibiotik berdasarkan resep dokter yang akan mendukung Anda dalam mematuhi pengobatan antibiotik sesuai anjuran dokter serta edukasi tambahan mengenai cara penggunaan yang benar.
Selain itu, kami juga memiliki rangkaian suplemen pendukung, produk desinfektan dan antiseptik untuk membantu menjaga kesehatan. Semua produk di Medicastore telah melalui proses seleksi dengan standar tinggi dan didukung oleh data klinis yang valid.
Saatnya Lindungi Diri dari Resistensi Bakteri!
Resistensi bakteri bukan hanya masalah medis, tapi juga ancaman nyata bagi kesehatan masyarakat. Dengan memahami penyebab, tanda dan cara pencegahannya, Anda telah mengambil langkah pertama untuk melindungi diri dan keluarga dari risiko infeksi yang sulit diobati.
Sebagai mitra kesehatan terpercaya, Medicastore menyediakan beragam produk yang membantu Anda menjaga kebersihan, meningkatkan daya tahan tubuh, dan menggunakan antibiotik secara tepat. Mulai dari suplemen, antiseptik, hingga informasi lengkap seputar penggunaan obat bisa diakses dengan mudah.
Kunjungi Medicastore atau unduh aplikasinya untuk mendapatkan produk kesehatan berkualitas dan edukasi terpercaya tentang penggunaan antibiotik yang bijak. Mari bersama cegah resistensi bakteri sejak hari ini!
Referensi:
- https://www.who.int/news/item/17-05-2024-who-updates-list-of-drug-resistant-bacteria-most-threatening-to-human-health
- https://ourworldindata.org/antibiotics
- https://www.who.int/news/item/29-04-2025-antibiotics-most-responsible-for-drug-resistance-are-overused---who-report
- https://pmc.ncbi.nlm.nih.gov/articles/PMC8841637/